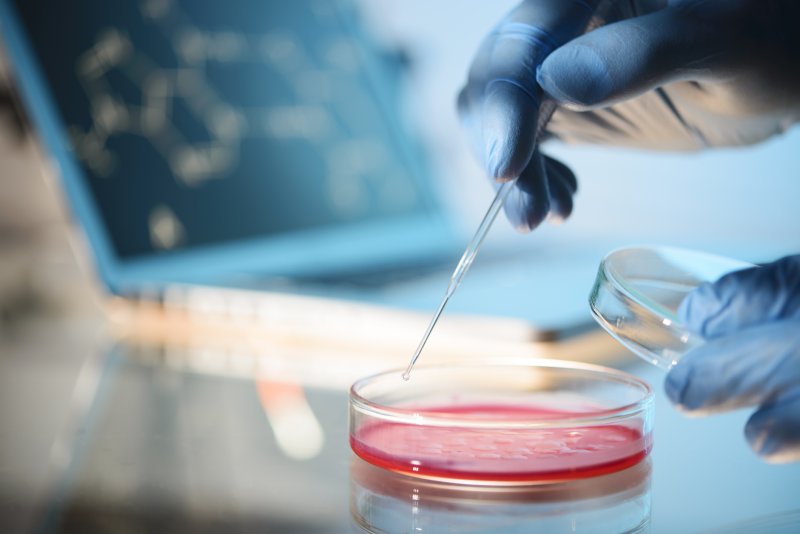

A new sexually transmitted fungal infection has been detected for the first time in the U.S., health experts announced Wednesday.
A study, published in the journal JAMA Dermatology on Wednesday, reported that the first known U.S. case of this new form of ringworm was discovered in a man from New York City in his 30s. The man had gone on a trip to England, Greece, and California, and when he came back to New York City, he developed tinea—a type of skin rash—on his penis, buttocks, and limbs.
The new form of ringworm is “highly contagious,” according to a New York University’s (NYU) Langone Health press release about the study. The study, which was conducted by experts at the medical center and elsewhere, found that the new fungal infection can take months to clear up, even when the patient receives treatment.
This fungus causes skin rashes, also known as tinea, which can spread on the face, limbs, groin, and feet, according to the press release. But unlike the neat circles typical with other forms of ringworm, the tinea caused by this new fungal infection may be mistaken for lesions caused by eczema, which could cause people not to seek the appropriate treatment right away, the press release said.
After some tests, health experts determined that the New York man had an infection caused by the species Trichophyton mentagrophytes type VII—a sexually transmitted form of ringworm that has spread across Europe, according to the press release. In 2023, France reported 13 cases of the infection, mostly in men who have sex with men. The man in New York City said that he had sex with multiple male partners on his trip, but none of them had reported similar symptoms, the press release said.
This is “the latest in a group of severe skin infections” to reach the U.S., Dr. Avrom Caplan, the study’s lead author and an assistant professor of dermatology at NYU’s Grossman School of Medicine, said in the press release.
Read More: STIs Are Increasing in Many Regions, New WHO Report Finds
“Since patients are often reluctant to discuss genital problems, physicians need to directly ask about rashes around the groin and buttocks, especially for those who are sexually active, have recently traveled abroad, and report itchy areas elsewhere on the body,” Dr. John Zampella, one of the study’s authors and an associate professor of dermatology at NYU’s Grossman School of Medicine, said in the press release.
These infections can be challenging to treat, but so far, they seem to be responding to standard treatments, including terbinafine, according to Zampella. Terbinafine is an oral tablet that treats fungal infections, according to the Mayo Clinic.
At the same time, Caplan warned that another skin infection that causes tinea is less responsive to standard treatments. In a study that was published in JAMA Dermatology in May, Caplan and other researchers examined Trichophyton indotinea, which is widespread in India and has now been reported across the globe. The first two U.S. cases of the infection were reported in 2023, according to the study.
Like Trichophyton mentagrophytes type VII, this infection also causes itchy and contagious rashes. But unlike Trichophyton mentagrophytes type VII, this infection often resists terbinafine.
Researchers advised medical practitioners to look out for symptoms of both infections in their patients, but added that rates are low so far in the U.S.
Get alerts on the biggest breaking news stories here

